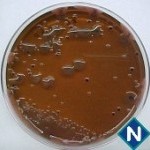
Imagem 3 - Ágar EMB
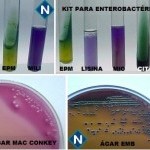
Imagem 5 - Bactéria 1
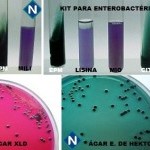
Imagem 6 - Bactéria 2

Caso nº 5
Caso Clínico #7
Local: Curitiba-PR
Mês / Ano: Maio/2001
Assuntos relacionados: Coprocultura. Sexo masculino. Criança
Quadro Clínico
Menino de 2 anos de idade, freqüentador diário de creche comunitária, com história de vômito e diarréia nas últimas 24 horas. Apresentava-se apático e letárgico, apesar da mãe referir que normalmente era uma criança esperta e alegre. Ao exame físico mostrou-se moderadamente desidratado, com temperatura de 37,5°C. Os exames de ouvido, nariz e garganta foram normais, bem como a ausculta pulmonar. Foi verificado abdomen flácido e sensibilidade moderada em baixo ventre.
O pediatria solicitou hemograma, uréia, eletrólitos, urocultura e coprocultura.
Com base nos dados clínicos e laboratoriais, propomos as seguintes questões para discussão do caso:
1. Como se deve orientar o paciente para a coleta de fezes para coprocultura?
2. Quais os sistemas de transporte de fezes disponíveis para coprocultura? Qual deles poderia ser considerado ideal?
3. Como deve ser processada inicialmente a amostra? Quais os critérios de escolha de meios para semeadura primária?
4. Quais são os meios em placa mais indicados para a semeadura primária de coprocultura?
5. Quais as provas bioquímicas que devem constar de um sistema de triagem de enteropatógenos em coprocultura e qual a finalidade delas?
6. Qual a utilidade da coloração de Gram de fezes destinadas a coprocultura?
7. Observando-se presença de leucócitos nas fezes, quais bactérias devem ser responsáveis pela diarréia?
8. Observando-se o crescimento bacteriano nas placas de isolamento primário acima, quais seriam os patógenos suspeitos?
9. Com base nas reações observadas nas imagens 5 e 6, quais os prováveis patógenos envolvidos neste caso?
10. Quais as provas adicionais necessárias para a identificação definitiva das bactérias envolvidas neste caso?
11. Como são conhecidos os tipos de Escherichia coli que causam gastroenterites? Qual o tipo provavelmente envolvido neste caso?
12. Quais são os tipos de infecção causados por Salmonella em humanos?
13. De quantas espécies consiste atualmente o gênero Salmonella?
14. Como pode ser feita a diferenciação das espécies de Shigella?
15. Seria indicado o uso de antimicrobianos para tratar este caso?
Referências Bibliográficas
1. PILONETTO, Marcelo & PILONETTO, Daniela V. Manual de Procedimentos Laboratoriais em Microbiologia. Curitiba, Ed. Microscience, 1998.
2. UNIVERSIDADE FEDERAL DO PARANÁ. Manual do Laboratório. Curitiba, Hospital de Clínicas, 1990.
3. MAHON, C.R. & MANUSELIS Jr., G. Textbook of Diagnostic Microbiology. Philadelphia, W.B. Saunders Company, 1995.
4. MILLER, J.M. A Guide to Specimen Management in Clinica Microbiology. Washington, ASM Press, 1996.
5. MURRAY, P.R.; ROSENTHAL, K.S.; KOBAYASHI, G.S.; PFALLER M.A. Microbiologia Médica, 3th ed. Rio de Janeiro, Editora Guanabara Koogan, 2000.
6. TRABULSI, L.R.; ALTERTHUM, F.; GOMPERTZ, O.F.; CANDEIAS, J.A.N. (Eds.) Microbiologia, 3ª ed. São Paulo, Editora Atheneu, 1999.
7. SCHAECHTER, M.; MEDOFF, G.; EISENSTEIN, B.I.; GUERRA, H. Microbiologia Mecanismos de las enfermedades infecciosas, 2da. Ed. Madrid, Editorial Medica Panamericana, 1994.
Dados Laboratoriais
1) Hemograma: normal.
2) Uréia: normal.
3) Eletrólitos: normal.
4) Urocultura: negativa.
5) Coprocultura: a amostra enviada ao laboratório continha grande quantidade de muco e foi semeada em ágar Mac Conkey, XLD, EMB e Hektoen (observar imagens 1, 2, 3 e 4).
Respostas da discussão
1. Coletar a amostra de fezes em recipiente bem limpo e transferir para frasco fornecido pelo laboratório contendo solução de transporte de fezes para coprocultura (glicerina tamponada) ou meio de transporte de fezes para coprocultura (Cary Blair). A quantidade de fezes deve ser calculada de acordo com a quantidade de solução ou meio de transporte contida no frasco. Procurar recolher os elementos de aspecto patológico como muco, pus e sangue. Misturar bem a amostra com a solução ou meio de transporte e conservar em temperatura ambiente até o envio ao laboratório, o que deverá ocorrer dentro de 24 horas.
2. São disponíveis no comércio 2 sistemas de transporte de fezes para coprocultura:
a) solução glicerina tamponada, para a pesquisa de patógenos comuns como Salmonella e Shigella;
b) meio de transporte de Cary-Blair, que poderia ser considerado como ideal, visto que permite o isolamento, além dos patógenos comuns, do Vibrio cholerae e Yersinia enterocolitica.
3. A amostra, ao chegar ao laboratório, deve ser inoculada em meios seletivos para bacilos gram-negativos e em caldo de enriquecimento para BGN. Os meios de cultura em placas devem ser escolhidos de acordo com o grau de seletividade, devendo ser usado um tipo mais seletivo e um tipo menos seletivo, pelo menos (exemplos: ágar EMB + ágar Hektoen; ágar Mac Conkey + ágar XLD).
4. Ágar EMB, ágar Mac Conkey, ágar XLD, ágar Hektoen, ágar SS.
5.
a) utilização de carboidratos (glicose, lactose) - para diferenciação de fermentadores e não-fermentadores
b) produção de indol - para diferenciação de E.coli
c) utilização de citrato - para exclusão de Enterobacter (que não é considerado enteropatógeno)
d) produção de urease - para exclusão de Proteus (que não é considerado enteropatógeno)
e) descarboxilação de aminoácidos - para caracterização de Salmonella e Shigella
f) produção de fenilalanina desaminase - para exclusão de Proteus
g) produção de gás sulfídrico - para diferenciação de Salmonella e exclusão de Proteus
h) verificação da motilidade - para diferenciação de Shigella
6. Avaliar a presença de leveduras (indicativo do uso de antimicrobianos) e leucócitos (indicativo da presença de bactérias invasivas).
7. Bactérias que invadem o epitélio intestinal: E.coli enteroinvasora (EIEC), Shigella, Salmonella.
8. Ágar XLD = colônias incolores transparentes com centro preto = suspeita de Salmonella
Ágar XLD = colônias amarelas com precipitado de bile = suspeita de E.coli
Ágar Mac Conkey = colônias rosadas médias com precipitado de bile = suspeita de E.coli
Ágar Mac Conkey = colônias transparentes amarelo pálidas = suspeita de não fermentador de lactose (Salmonella ou Shigella)
Ágar EMB = colônias com centro preto e brilho metálico = suspeita de E.coli
Ágar EMB = colônias incolores = suspeita de não fermentador de lactose (Salmonella e Shigella)
Ágar Hektoen = colônias incolores com centro preto = suspeita de Salmonella
Ágar Hektoen = colônias amarelas com precipitado de bile = suspeita de E.coli
9. Bactéria 1
TSI = glicose + c/gás, lactose +, H2S –
EPM + MILi = glicose + c/gás, TDA -, H2S -, lisina +, motilidade + e indol +
Kit de enterobactérias = glicose + c/gás, TDA -, H2S -, uréia -, lisina +, motilidade+, indol +, ornitina + citrato -, rhamnose +
Bactéria provável = E.coli
Bactéria 2
TSI = glicose+ c/gás, lactose -, H2S +
EPM + MILi = glicose + c/gás, TDA -, H2S +, lisina +, motilidade + e indol -
Kit de enterobactérias = glicose + c/gás, TDA -, H2S +, uréia -, lisina +, motilidade+, indol -, citrato -, rhamnose +
Bactéria provável = Salmonella
10. Provas sorológicas com soros grupo-específicos para a E.coli e soros somáticos e flagelares para a Salmonella.
11. E.coli enteroinvasora (EIEC)
E.coli enterotoxigênica (ETEC)
E.coli enteropatogênica (EPEC)
E.coli entero-hemorrágica (EHEC)
E.coli enteroagregativa (EAggEC)
E.coli que adere difusamente (DAEC)
O tipo provavelmente envolvido neste caso é a E.coli enteropatogênica.
12. Três tipos gerais de infecção:
- gastroenterite e diarréia (infecções limitadas à mucosa gastrointestinal)
- bacteremia e infecções extraintestinais (disseminadas a partir do trato gastrointestinal)
- febre entérica (febre tifóide), infecção grave caracterizada por febre prolongada e envolvimento de múltiplos órgãos e sistemas
13. Duas espécies: S.enterica e S.bongori.
14. Pela aglutinação com soros grupo-específicos para as 4 espécies patogênicas para humanos (S.flexneri, S.sonnei, S.boydii, S.dysenteriae)
15. O uso de antimicrobianos geralmente não é indicado para o tratamento das diarréias não complicadas.